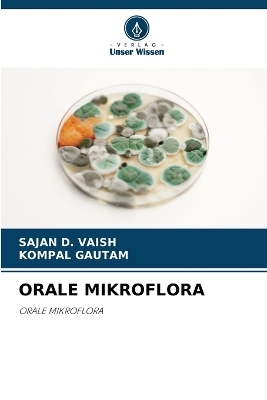
Orale Mikroflora - Sajan D Vaish, KOMPAL GAUTAM

Orale Mikroflora
Seiten
2024
Verlag Unser Wissen
978-620-8-22045-7 (ISBN)
Verlag Unser Wissen
978-620-8-22045-7 (ISBN)
- Titel nicht im Sortiment
- Artikel merken
Die Mundhöhle ist eines der komplexesten mikrobiellen Habitate. Im menschlichen Körper bezieht sich die Terminologie, die zur Beschreibung von Mikroorganismen in der Mundhöhle verwendet wird, auf die orale Mikroflora. In Zukunft könnte es möglich sein, die Behandlung gezielter auf bestimmte Krankheitserreger auszurichten, oder es könnten einfallsreichere Ansätze zur Vorbeugung von Krankheiten eingesetzt werden. In diesem Zusammenhang wird das Ergebnis der aktuellen klinischen Studie mit Bakteriocin-produzierenden nicht säurebildenden, aber leicht konkurrierenden Stämmen von S. Mutans von großer Bedeutung sein.
Ich selbst, Dr. Sajan d. Vaish, bin eine freundliche, entschädigte, ehrliche und fleißige Tochter eines Bauern. Ich glaube an harte Arbeit mit Beständigkeit.
| Erscheinungsdatum | 26.10.2024 |
|---|---|
| Sprache | deutsch |
| Maße | 152 x 229 mm |
| Gewicht | 136 g |
| Themenwelt | Medizin / Pharmazie ► Zahnmedizin |
| Schlagworte | caries • Karies • Microflora • Mundhöhle • Oral cavity • Periapical infection • PERIAPIKALE INFEKTION |
| ISBN-10 | 620-8-22045-9 / 6208220459 |
| ISBN-13 | 978-620-8-22045-7 / 9786208220457 |
| Zustand | Neuware |
| Informationen gemäß Produktsicherheitsverordnung (GPSR) | |
| Haben Sie eine Frage zum Produkt? |
Mehr entdecken
aus dem Bereich
aus dem Bereich
Tiergestützte Therapie in der Zahnmedizin | Orale Medizin Band 2
Buch | Softcover (2025)
Lehmanns Media (Verlag)
CHF 27,90


